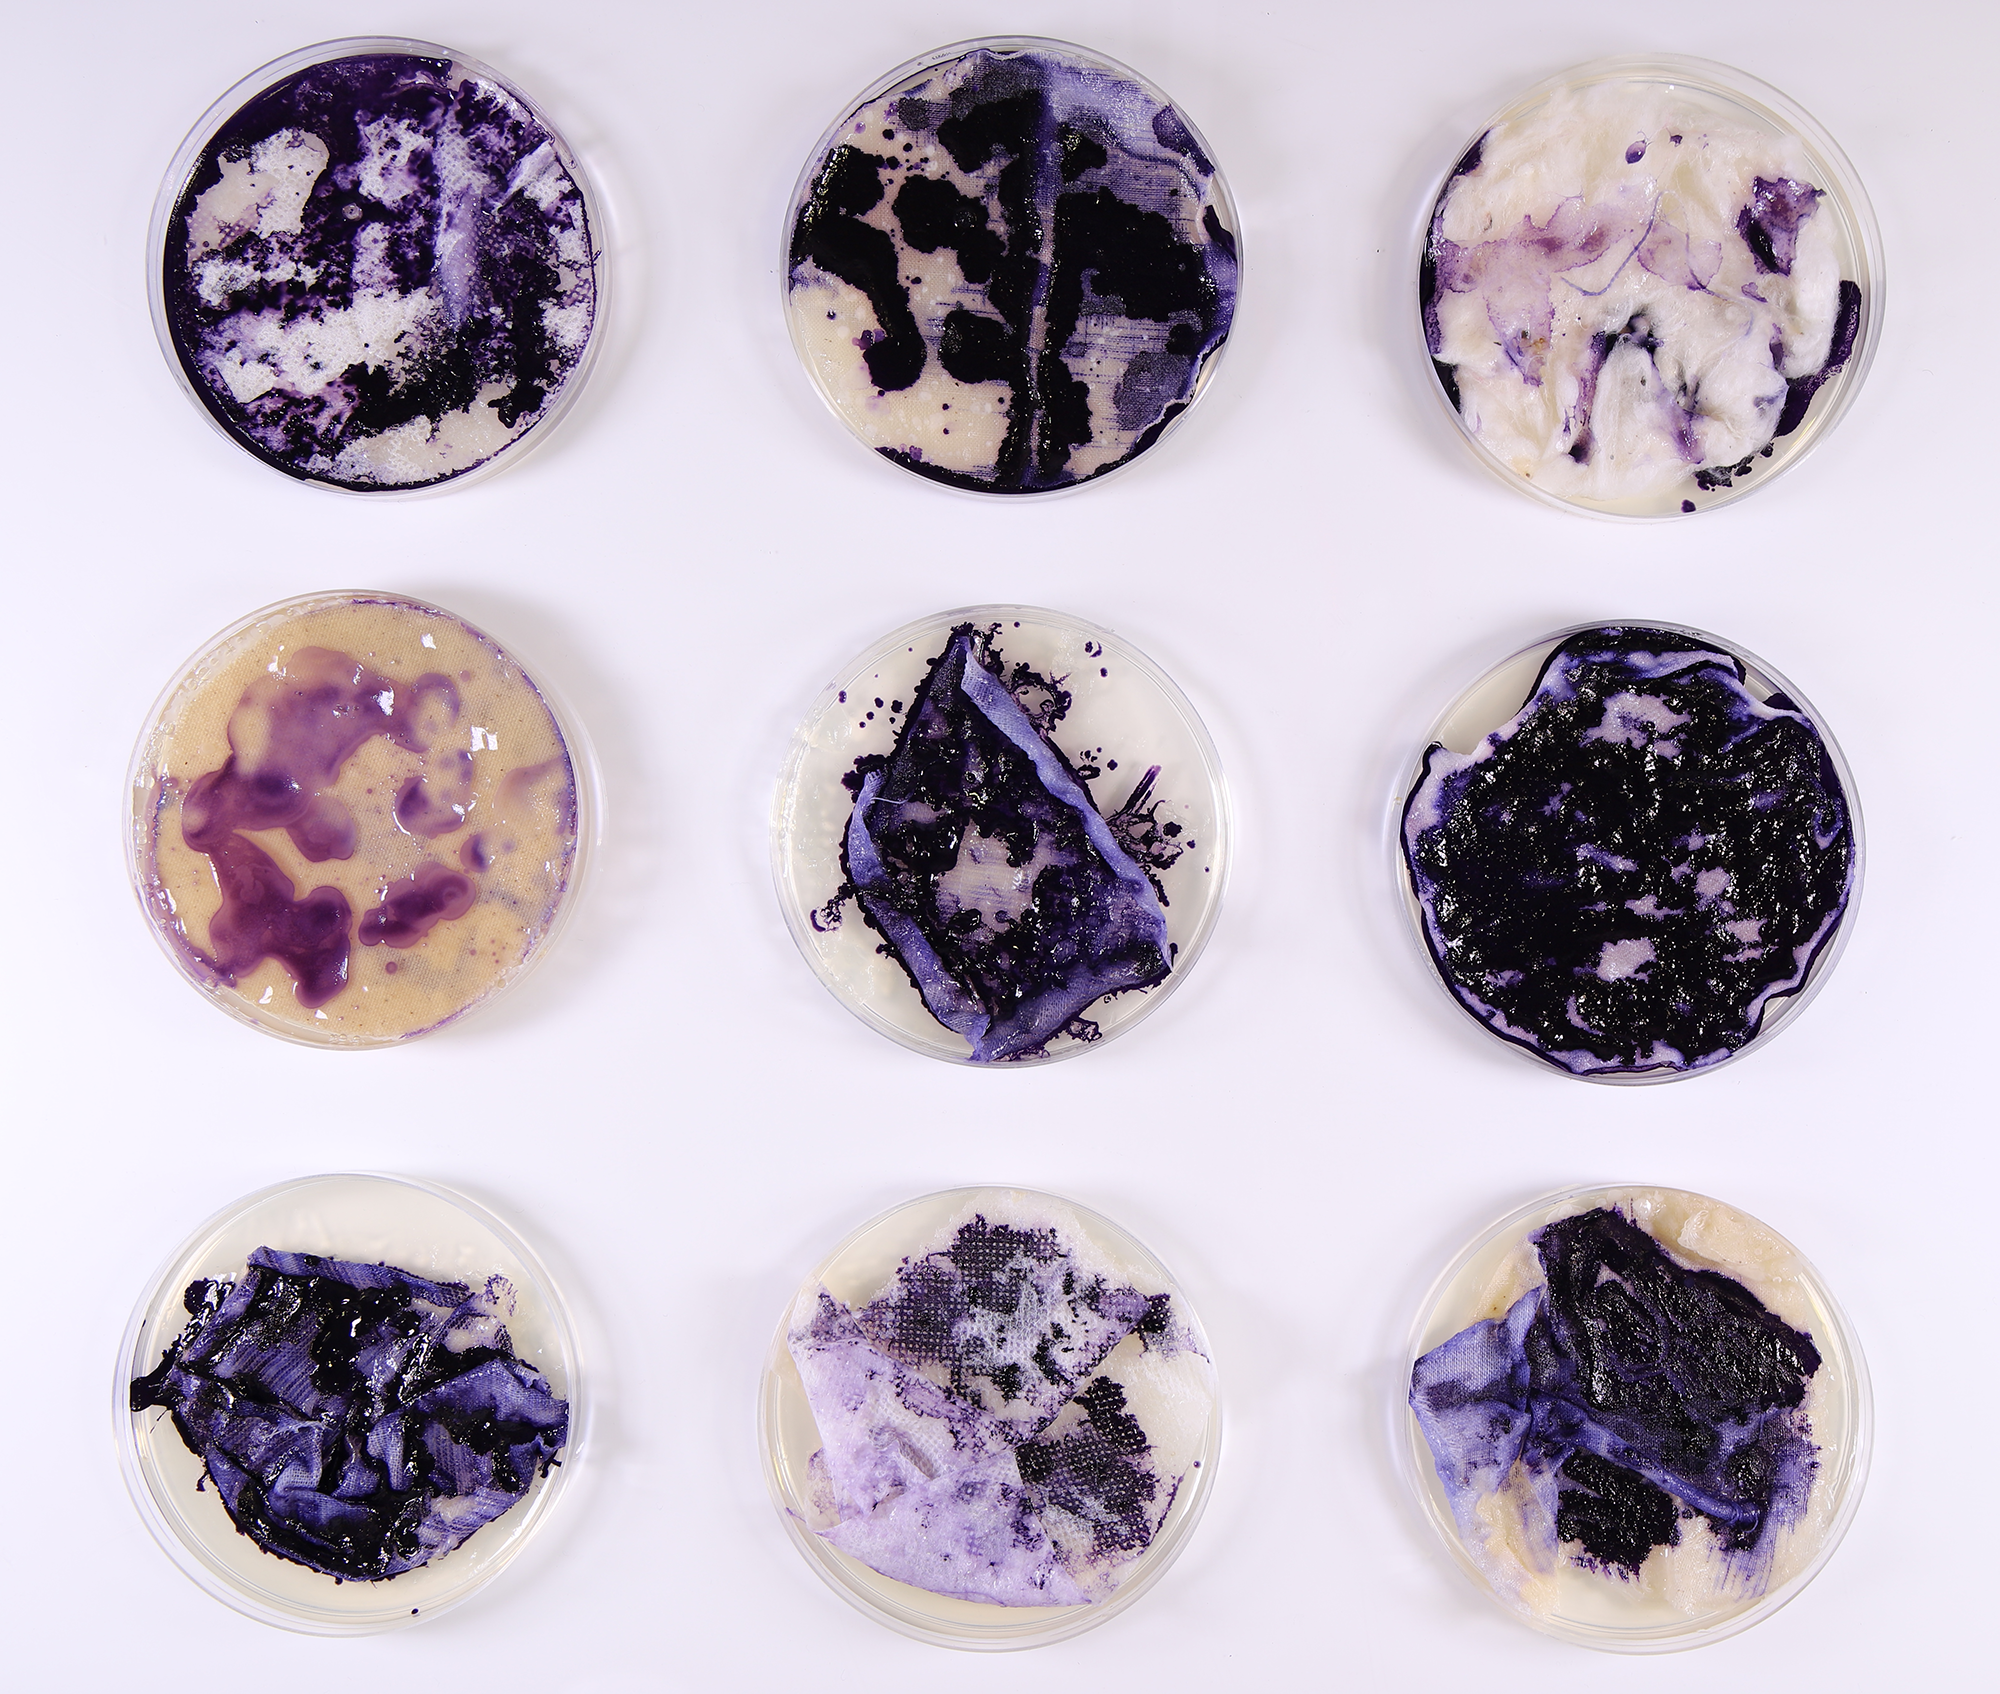

BACTERIAL DYES
Using pigments secreted from bacteria as a non-toxic dyeing technique
2020
What: Testing the growth of Janthinobacterium lividum, a bacteria producing the purple pigment Violacein, on different fabrics as a potentially more sustainable dyeing technique for the fashion industry
Why: Saving water consumption, avoiding toxic dyeing substances, better biodegradability
How: Lab experiments on different types of fabrics, inoculation techniques, autoclaving techniques, washing methods
Where: London, UK
This project was an exploration of alternative dyeing techniques for fashion applications, which nowadays is one of the most polluting and water consuming industries, spreading toxic substances in the environment and causing a dramatic impact. Bacteria pigments can be a more sustainable, natural and biodegradable alternative which opens up a variety of creative possibilities.
Variables tested:
Fabrics: viscose, cotton calico, tyvek, wool
Inoculation methods: paint / pipette
Autoclave methods: glass petri dish / paper bag
Washing methods: cold water / 10% salt solution / 1% sodium dodecyl sulfate
Steps:Liquid culture preparation | Fabrics sterilization | Agar solution preparation | Bacteria inoculation | Growth over 6 days | Autoclaving the samples | Washing and drying | Results evaluation and comparison, including microscopic observation.



liquid culture preparation & bacterial growth




agar solution preparation, bacterial innoculation

images of bacterial growth over 6 days: 16.01.2020 - 17.01.2020 - 21.01.2020







Fabric samples after autoclaving, washing, drying



Microscopic view of a bacteria-dyed tyvek dry sample

Project conducted with Cassandra Quinn, Carolina Kyvik Ruiz, Marie Melcore, Eleonora Rombolà - MA Biodesign, CSM UAL